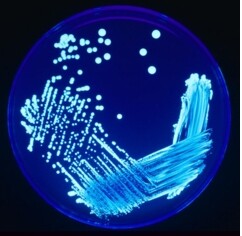

Το Υπουργείο Υγείας της Ισπανίας βάρεσε το καμπανάκι του κινδύνου και έδωσε οδηγίες πρόληψης στους Μαδριλένους, μιας και η νόσος των λεγεωνάριων έχει πλήξει την ισπανική πρωτεύουσα. Πιο συγκεκριμένα 23 άνθρωποι έχουν προσβληθεί από τη νόσο κι ένας έχει χάσει τη ζωή του. Οι Ισπανοί επιστήμονες και γιατροί δεν έχουν εντοπίσει ακόμα από που προέρχεται η νόσος και ψάχνουν να βρουν τι συνδέει τους προσβεβλημένους από τη νόσο. Η νόσος των λεγεωνάριων ή των air condition όπως λέγεται η νόσος λόγω της προέλευσης της έχει τα ίδια συμπτώματα με την πνευμονία και χρόνο επώασης μια βδομάδα με 10 μέρες περίπου. Είναι μια μορφή πνευμονίας που την προκαλούν βακτήρια που ζουν στα σταγονίδια του νερού. Τα συμπτώματα είναι το συνάχι, ο πυρετός και ο ξερόβηχας με πόνο στο λαιμό. Την ασθένεια την εντόπισαν το 1976 στην αμερικανικής λεγεώνα (εξού και η ονομασία) στη Φιλαδέλφεια της Αμερικής.
ΔΙΑΒΑΖΟΝΤΑΙ ΤΩΡΑ

Chios Pass 2026 - Kythira Pass 2026: Πού κάνω αίτηση - Ανοιχτή η πλατφόρμα

Κυκλοφοριακές ρυθμίσεις στην Αθήνα την επόμενη Κυριακή - Τι ώρα και ποιοι δρόμοι κλείνουν

Η συγγραφέας πίσω από τα «Μπούτια και Διανόηση»

Από τη μεσαιωνική Μπολόνια στους ουρανοξύστες της Αθήνας

Mantility: Μαντίλια που δεν έχεις ξαναδεί

σχόλια